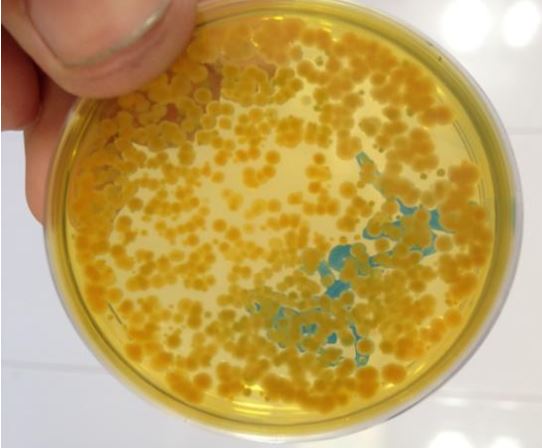

Trong ao có sứa! Làm sao cho hết bây giờ, có ảnh hưởng tôm không?
Sứa (Scyphozoa) là một lớp nhuyễn thể, thân mềm, sống ở môi trường nước, thuộc giới động vật. Sứa nước sẽ tiết ra chất nhầy làm giảm khuếch tán Oxy trong nước.
Các chất nhầy này còn bám vào thức ăn của tôm làm suy giảm khả năng bắt mồi của tôm. Sứa tiết ra các chất độc làm tôm suy yếu hoặc chết hàng loạt.
Ảnh sứa nước (sưu tầm)
Trong nghề nuôi trồng thủy sản hiện nay nói chung cũng như nghề nuôi tôm nói riêng thì với những mô hình nuôi có mật độ cao, việc quản lý về môi trường nước, đáy ao trở nên nhiều hơn. Lượng chất thải, phân thừa cũng song song nhiều hơn. Ngoài ra, với điều kiện thời tiết nắng nóng kéo dài, hạn mặn đồng loạt ở hầu hêt các tỉnh Đồng bằng Sông Cửu Long, có khu vực độ mặn lên đến trên 40 phần nghìn, từ đó tạo điều kiện cho vi khuẩn, nấm gây hai và kí sinh trùng,.. bùng phát mạnh.
Với mức hạn mặn như hiện tại, không phải khu vực nào cũng có nước ngọt để sử dụng (pha loãng). Trong khi tất cả các dòng vi sinh ở ngưỡng độ mặn cao thì tác dụng sẽ bị hao mòn. Khi đó, việc vừa phải lấn áp và ức chế vi khuẩn, nấm, kí sinh trùng, nguyên sinh động vật và kể cả việc ngăn ngừa sứa nước trong ao nuôi cũng trở nên giảm đi phần nào sức mạnh.
Ảnh Nấm bám lên sàng tôm ăn “nhá”.
Chính vì lẽ đó, BRONOL là một trong những sản phẩm có khả năng tiêu diệt ngoại kí sinh trùng, diệt khuẩn, diệt nấm và trên hết là khả năng tiêu diệt sứa nước trong ao nuôi nhanh chóng mà vẫn không làm tôm bị sốc.
Sản phẩm Bronol - Diệt khuẩn, nấm, nguyên sinh động vật, sứa nước, ký sinh trùng trong ao nuôi tôm.
Thành phần chính làm nên BRONOL đó chính là Glutaraldehyde. Glutaraldehyde được đưa vào sử dụng từ những năm 1960. Nó nằm trong danh sách các thuốc thiết yếu của Tổ chức Y tế Thế giới, tức là nhóm các loại thuốc hiệu quả và an toàn nhất cần thiết trong một hệ thống y tế (Booth, Anne 1998. Sterilization of Medical Devices). lutaraldehyde có hiệu quả chống lại một loạt các vi sinh vật kể cả bào tử của chúng (WHO Model Formulary 2008 (PDF). World Health Organization. 2009. tr. 323, 325. ISBN 9789241547659).
Sản phẩm Bronol - Diệt khuẩn, nấm, nguyên sinh động vật, sứa nước, ký sinh trùng trong ao nuôi tôm.
Hiện nay, BRONOL là chất thay thế cho các loại chất cấm trước đây trị nấm như: Xanh Malachite, Trifluralin, Olan,.. Và được các quốc gia nhập khẩu mặt hàng thủy sản Việt Nam như Mỹ, Nhật và Liên minh Châu âu khuyến dùng. Với nấm BRONOL là một chất đặc trị. Với vi khuẩn mang gam âm và mang gam dương thì BRONOL là một chất diệt và ức chế nhanh, mạnh. Mặt khác, BRONOL sau khi phát huy tác dụng, sẽ phân giải nhanh dưới các tác nhân nhiệt độ, oxy nên không tồn lưu, không ảnh hưởng đến môi trường đang xử lý, cũng như vấn đề sốc tôm. Tính tác động, làm ảnh hưởng đến môi trường ao nuôi tôm (như làm chết tảo) làm thay đổi yếu tố môi trường như pH, kiềm, Ca hay Mg trong ao tôm là không có, rất thấp hoặc không đáng kể.
Khuẩn TRƯỚC khi tạt BRONOL (Vibrio >29.000 Cfu/ml)
Khuẩn SAU khi tạt BRONOL ( Vibrio 6.450 Cfu/ml)
Anh Võ Thanh Tuấn, nhân viên kỹ thuật của Công ty TNHH Thương Mại XNK Mỹ Bình đã thực hiện kiểm chứng liều dùng tại khu nuôi của công ty (An Minh – Kiên Giang) chia sẽ “Liều dùng BRONOL với mục đích phòng và ngừa khuẩn, nấm trong ao tương ứng 1 lít/1000m3 nước ao. Trong
trường hợp khuẩn, nấm cao ta có thể thực hiện 2-3 lít/ 1000m3, hoàn toàn không gây sốc tôm. Đối với trường hợp sứa nước ta thực hiện tạt 1 lít/1000m3 nước, 24h sau kiểm tra lại nếu còn ta thực hiện lần 2”. Anh chia sẽ thêm “ Liều dùng diệt sứa nước không phải luôn lúc nào cũng là 1 lít/1000m3,
mà nó còn tùy thuộc vào mật độ sứa trong ao nuôi và sự phát triển của nó mạnh hay yếu”.
Tham khảo thêm về sản phẩm BRONOL tại đây.
Mọi thắc mắc về kỹ thuật hay thông tin sản phẩm trong bài, bà con vui lòng liên hệ qua Hotline 0911 383 533 để được các kỹ thuật viên của công ty trực tiếp giải đáp.
Chúc quý bà con có vụ mùa bội thu!




